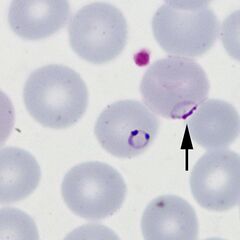
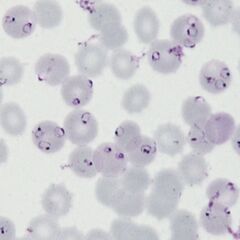

P.falciparum early trophozoites gallery: Difference between revisions
From haematologyetc.co.uk
No edit summary |
No edit summary |
||
| Line 10: | Line 10: | ||
{| class="wikitable" style="border-style: solid; border-width: 5px; color:black" | {| class="wikitable" style="border-style: solid; border-width: 5px; color:black" | ||
|colspan="1" style = "font-size:100%; color:black; background: | |colspan="1" style = "font-size:100%; color:black; background: #ffffcc"|'''''P.falciparum'' gallery of early trophozoites''''' | ||
|} | |} | ||
| Line 16: | Line 16: | ||
<span style="font-size:95%">'''Summary'''</span> | <span style="font-size:95%">'''Summary'''</span> | ||
<span style="font-size:95%">At this stage we look for typical (and often frequent) delicate rings within red cells that have normal (or slightly crenated) appearance. Forms often seen in this species include accolé forms, double chromatin dot forms, and multiple parasites within infected red cells. | <span style="font-size:95%">At this stage we look for typical (and often frequent) delicate rings within red cells that have normal (or slightly crenated) appearance. Forms often seen in this species include accolé forms, double chromatin dot forms, and multiple parasites within infected red cells. | ||
---- | |||
<gallery mode="traditional" widths=240px heights=240px> | <gallery mode="traditional" widths=240px heights=240px> | ||
File:PFET1p.jpg|<span style="font-size:80%">'''Fine ring form''' The small and delicate form of this species</span>|link={{filepath:PFET1p.jpg}} | File:PFET1p.jpg|<span style="font-size:80%">'''Fine ring form''' The small and delicate form of this species</span>|link={{filepath:PFET1p.jpg}} | ||
Revision as of 21:57, 18 March 2024
Navigation
(click blue highlighted text to return to page)
Malaria main index
>Species identification: summary page
>>P.falciparum: morphology
>>>This page: P.falciparum early trophozoites gallery
| P.falciparum gallery of early trophozoites |
Summary
At this stage we look for typical (and often frequent) delicate rings within red cells that have normal (or slightly crenated) appearance. Forms often seen in this species include accolé forms, double chromatin dot forms, and multiple parasites within infected red cells.
"